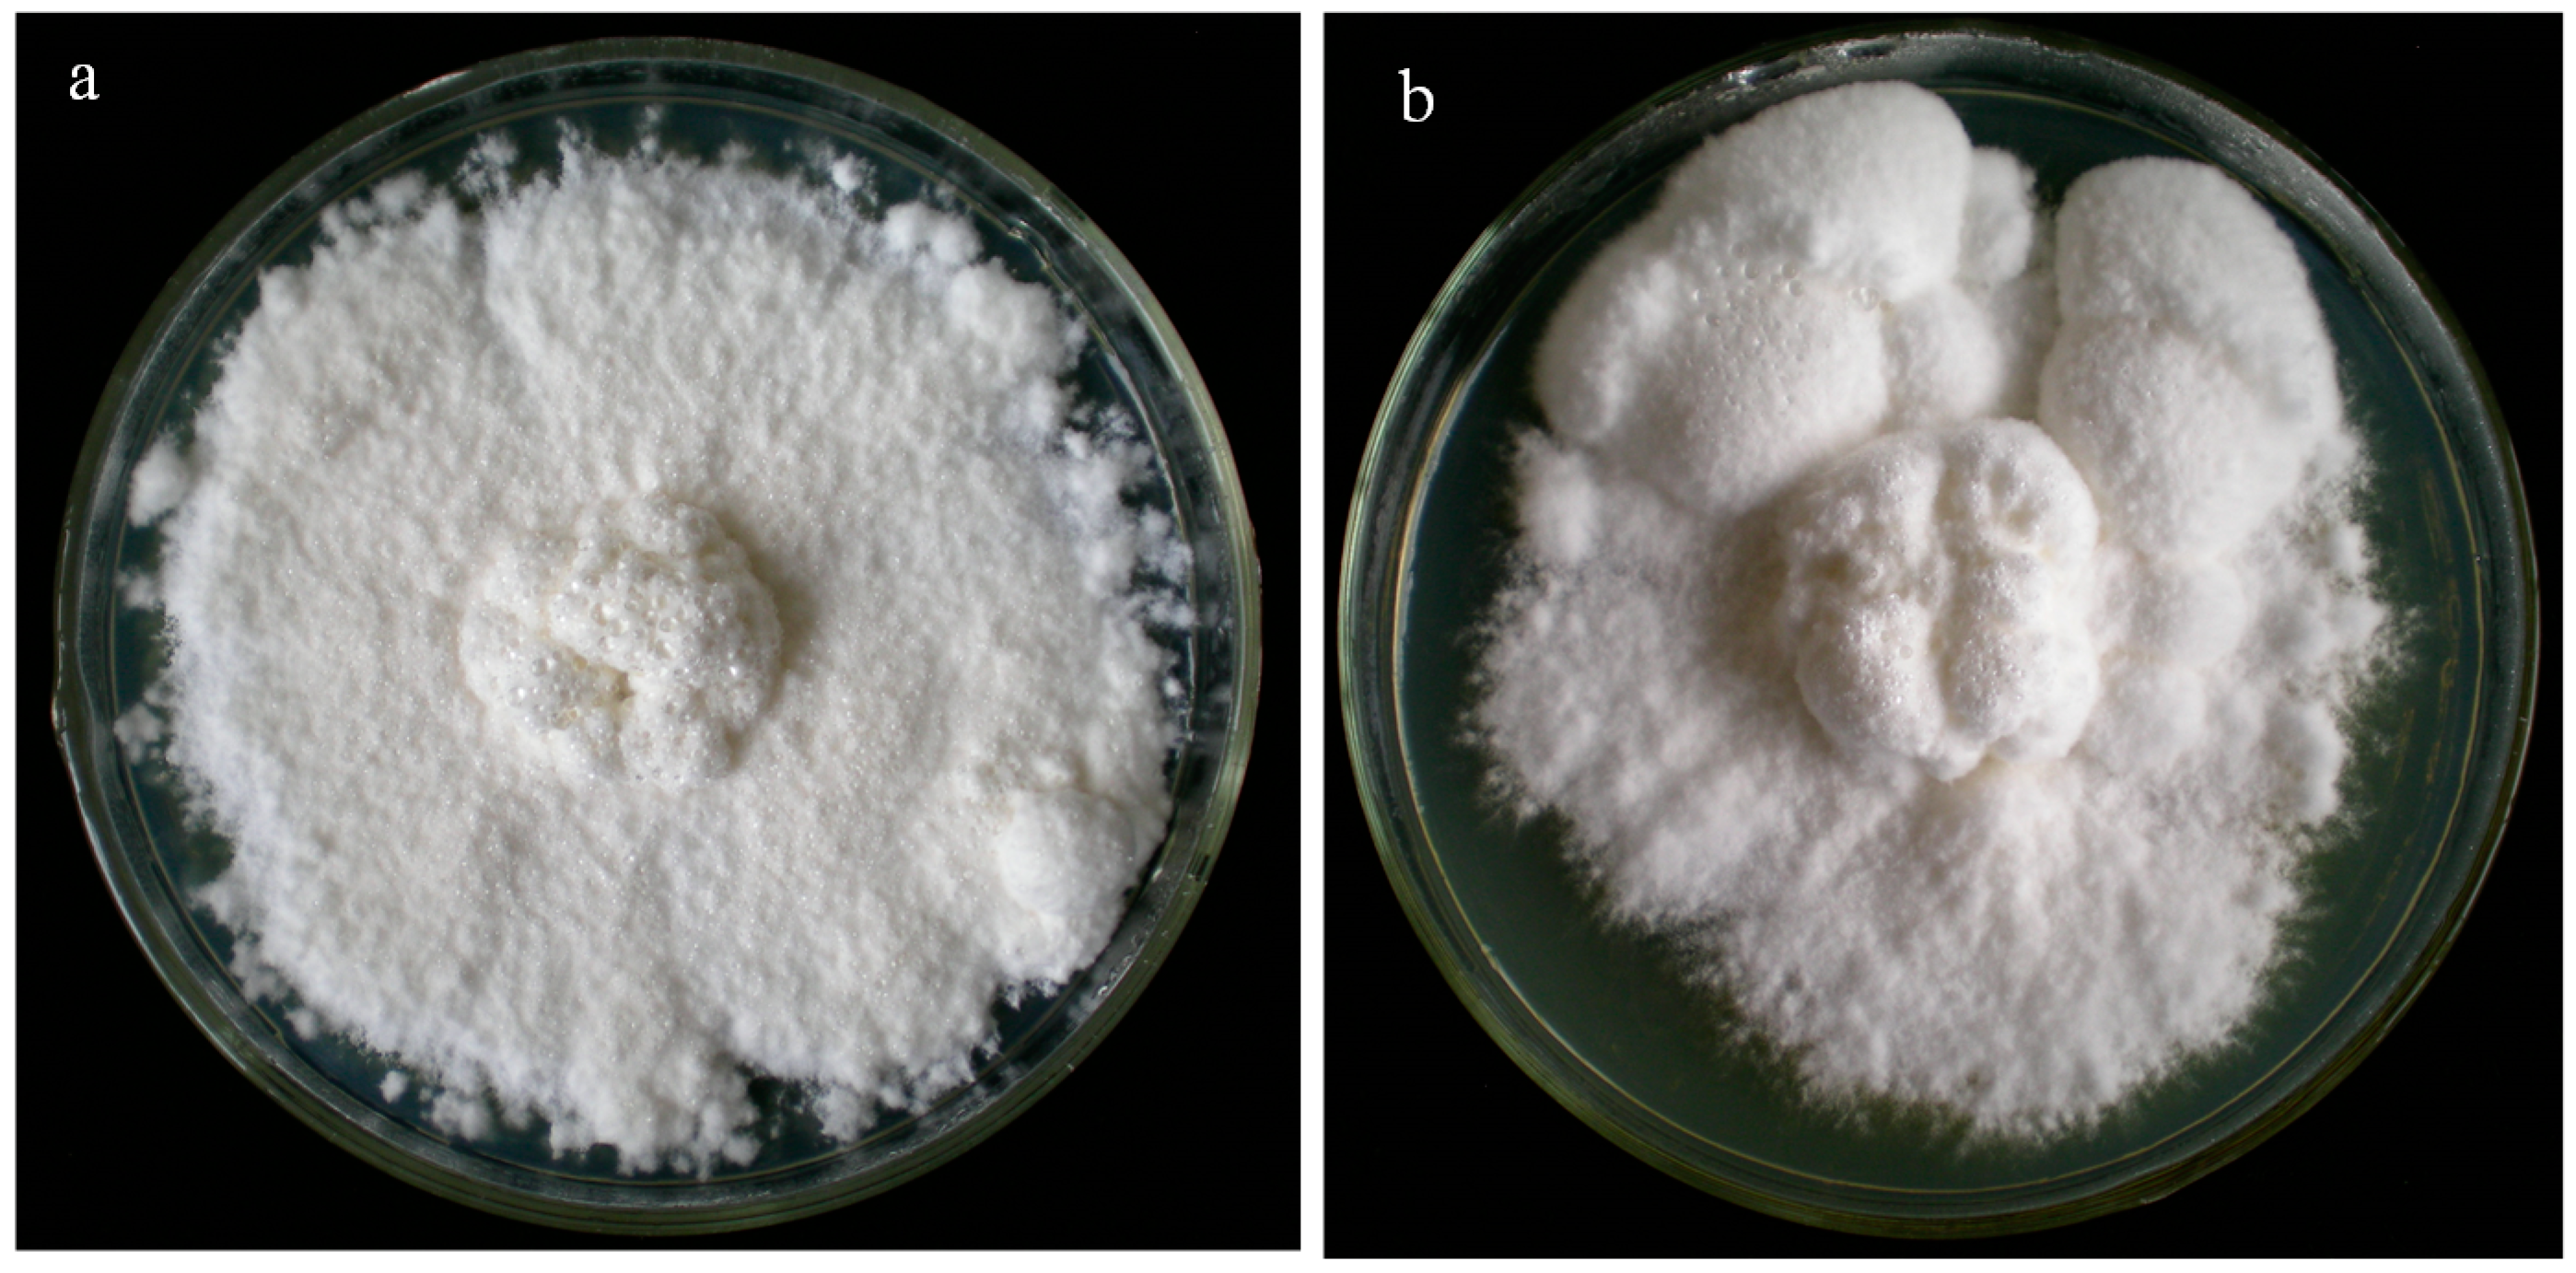
Ijms 15 15951 g001 1024

ESTs Analysis of Putative Genes Engaged in Polyporus umbellatus Sclerotial Development
Abstract
:1. Introduction
2. Results and Discussion
2.1. Morphological Identification
2.2. EST (Expressed Sequence Tag) Assembly
2.3. Functional Characterization of EST Data Set


2.4. Transcription Expression Patterns of Candidate Genes through RT-PCR Assay



3. Experimental Section
3.1. Sclerotial Material Preparation
3.2. RNA and mRNA Isolation
3.3. Suppression Subtractive Hybridization (SSH)
3.4. cDNA Sequencing and EST Analyses
3.5. Real-Time qPCR Analysis
4. Conclusions
Acknowledgments
Author Contributions
Conflicts of Interest
References
- Zhao, Y.-Y. Traditional uses, phytochemistry, pharmacology, pharmacokinetics and quality control of Polyporus umbellatus (Pers.) Fries: A review. J. Ethnopharmacol 2013, 149, 35–48. [Google Scholar] [CrossRef]
- Lee, J. Colored Korean Mushrooms; Academic Publicing Co., Ltd.: Seoul, Korean, 1988; pp. 204–213. [Google Scholar]
- Xu, J. Chinese Medicinal Mycology; (in Chinese). Publishing House of Peking Union Medical College and China Medical University: Beijing, China, 1997. [Google Scholar]
- Xing, Y.-M.; Chen, J.; Lv, Y.-L.; Liang, H.-Q.; Guo, S.-X. Determination of optimal carbon source and pH value for sclerotial formation of Polyporus umbellatus under artificial conditions. Mycol. Prog. 2011, 10, 121–125. [Google Scholar]
- Sun, Y.; Ji, Z.; Zhao, Y.; Liang, X.; Hu, X.; Fan, J. Enhanced distribution and anti-tumor activity of ergosta-4,6,8(14),22-tetraen-3-one by polyethylene glycol liposomalization. J. Nanosci. Nanotechnol. 2013, 13, 1435–1439. [Google Scholar] [CrossRef]
- Yuan, D.; Mori, J.; Komatsu, K.-I.; Makino, T.; Kano, Y. An anti-aldosteronic diuretic component (drain dampness) in Polyporus sclerotium. Biol. Pharm. Bull. 2004, 27, 867–870. [Google Scholar] [CrossRef]
- Zhao, Y.-Y.; Xie, R.-M.; Chao, X.; Zhang, Y.; Lin, R.-C.; Sun, W.-J. Bioactivity-directed isolation, identification of diuretic compounds from Polyporus umbellatus. J. Ethnopharmacol. 2009, 126, 184–187. [Google Scholar] [CrossRef]
- Zhao, Y.-Y.; Shen, X.; Chao, X.; Ho, C.C.; Cheng, X.-L.; Zhang, Y.; Lin, R.-C.; Du, K.-J.; Luo, W.-J.; Chen, J.-Y. Ergosta-4,6,8(14),22-tetraen-3-one induces G2/M cell cycle arrest and apoptosis in human hepatocellular carcinoma HepG2 cells. Biochim. Biophys. Acta BBA Gen. Subj. 2011, 1810, 384–390. [Google Scholar]
- Zhao, Y.-Y.; Zhang, L.; Mao, J.R.; Cheng, X.H.; Lin, R.C.; Zhang, Y.; Sun, W.J. Ergosta-4,6,8(14),22-tetraen-3-one isolated from Polyporus umbellatus prevents early renal injury in aristolochic acid-induced nephropathy rats. J. Pharm. Pharmacol. 2011, 63, 1581–1586. [Google Scholar] [CrossRef]
- Zhao, Y.-Y.; Cheng, X.-L.; Cui, J.-H.; Yan, X.-R.; Wei, F.; Bai, X.; Lin, R.-C. Effect of ergosta-4,6,8(14),22-tetraen-3-one (ergone) on adenine-induced chronic renal failure rat: A serum metabonomic study based on ultra performance liquid chromatography/high-sensitivity mass spectrometry coupled with MassLynx i-FIT algorithm. Clin. Chim. Acta 2012, 413, 1438–1445. [Google Scholar] [CrossRef]
- Chen, D.-Q.; An, J.-M.; Feng, Y.-L.; Tian, T.; Qin, X.-Y.; Zhao, Y.-Y. Cloud-point extraction combined with liquid chromatography for the determination of ergosterol, a natural product with diuretic activity, in rat plasma, urine, and feces. J. Anal. Methods Chem. 2013, 2013. [Google Scholar] [CrossRef]
- Zhao, Y.-Y.; Zhang, L.; Long, F.-Y.; Cheng, X.-L.; Bai, X.; Wei, F.; Lin, R.-C. UPLC-Q-TOF/HSMS/MSE-based metabonomics for adenine-induced changes in metabolic profiles of rat feces and intervention effects of ergosta-4,6,8(14),22-tetraen-3-one. Chem. Biol. Interact. 2013, 201, 31–38. [Google Scholar] [CrossRef]
- Papapostolou, I.; Sideri, M.; Georgiou, C.D. Cell proliferating and differentiating role of H2O2 in Sclerotium rolfsii and Sclerotinia sclerotiorum. Microbiol. Res. 2013, 169, 527–532. [Google Scholar] [CrossRef]
- Zhao, Y.-Y.; Chao, X.; Zhang, Y.; Lin, R.-C.; Sun, W.-J. Cytotoxic steroids from Polyporus. Planta Med. 2010, 76, 1755–1758. [Google Scholar] [CrossRef]
- Zhao, Y.-Y.; Cheng, X. L.; Zhang, Y.; Zhao, Y.; Lin, R.C.; Sun, W.J. Simultaneous determination of eight major steroids from Polyporus umbellatus by high-performance liquid chromatography coupled with mass spectrometry detections. Biomed. Chromatogr. 2010, 24, 222–230. [Google Scholar]
- Peng, K.; Lan, L.S.; Yan, W.X.; Jie, S.L.; Wu, Y.J.; Hua, Z.Y.; Shu-Chen, L. Polyporus umbellatus polysaccharides ameliorates carbon tetrachloride-induced hepatic injury in mice. Afr. J. Pharm. Pharmacol. 2012, 6, 2686–2691. [Google Scholar]
- Liu, Y.-Y.; Guo, S. Nutritional factors determining sclerotial formation of Polyporus umbellatus. Lett. Appl. Microbiol. 2009, 49, 283–288. [Google Scholar] [CrossRef]
- Huang, H.-C.; Liu, Y.-C. Enhancement of polysaccharide production by optimization of culture conditions in shake flask submerged cultivation of Grifola umbellata. J. Chin. Inst. Chem. Eng. 2008, 39, 307–311. [Google Scholar] [CrossRef]
- Liu, Y.-Y.; Guo, S.-X. Involvement of Ca2+ channel signaling in sclerotial formation of Polyporus umbellatus. Mycopathologia 2010, 169, 139–150. [Google Scholar] [CrossRef]
- Berardini, T.Z.; Mundodi, S.; Reiser, L.; Huala, E.; Garcia-Hernandez, M.; Zhang, P.; Mueller, L.A.; Yoon, J.; Doyle, A.; Lander, G. Functional annotation of the Arabidopsis genome using controlled vocabularies. Plant Physiol. 2004, 135, 745–755. [Google Scholar] [CrossRef]
- Tatusov, R.L.; Koonin, E.V.; Lipman, D.J. A genomic perspective on protein families. Science 1997, 278, 631–637. [Google Scholar] [CrossRef]
- Scott, B.; Eaton, C.J. Role of reactive oxygen species in fungal cellular differentiations. Curr. Opin. Microbiol. 2008, 11, 488–493. [Google Scholar] [CrossRef]
- Takano, M.; Nakamura, M.; Yamaguchi, M. Glyoxal oxidase supplies hydrogen peroxide at hyphal tips and on hyphal wall to manganese peroxidase of white-rot fungus Phanerochaete crassa WD1694. J. Wood Sci. 2010, 56, 307–313. [Google Scholar] [CrossRef]
- Niimura, Y. The NADH oxidase-prx system in Amphibacillus Xylanus. In Peroxiredoxin Systems; Springer: Berlin, Germany, 2007; pp. 195–200. [Google Scholar]
- Harel, A.; Gorovits, R.; Yarden, O. Changes in protein kinase A activity accompany sclerotial development in Sclerotinia sclerotiorum. Phytopathology 2005, 95, 397–404. [Google Scholar] [CrossRef]
- Dupuy, C.; Virion, A.; Ohayon, R.; Kaniewski, J.; Deme, D.; Pommier, J. Mechanism of hydrogen peroxide formation catalyzed by NADPH oxidase in thyroid plasma membrane. J. Biol. Chem. 1991, 266, 3739–3743. [Google Scholar]
- Georgiou, C.D. Lipid peroxidation in Sclerotium rolfsii: A new look into the mechanism of sclerotial biogenesis in fungi. Mycol. Res. 1997, 101, 460–464. [Google Scholar] [CrossRef]
- Chen, C.; Dickman, M.B. cAMP blocks MAPK activation and sclerotial development via Rap-1 in a PKA-independent manner in Sclerotinia sclerotiorum. Mol. Microbiol. 2005, 55, 299–311. [Google Scholar] [CrossRef]
- Bucci, C.; Parton, R.G.; Mather, I.H.; Stunnenberg, H.; Simons, K.; Hoflack, B.; Zerial, M. The small GTPase rab5 functions as a regulatory factor in the early endocytic pathway. Cell 1992, 70, 715–728. [Google Scholar] [CrossRef]
- Kennedy, M.A.; Johnson, T.A.; Lees, N.D.; Barbuch, R.; Eckstein, J.A.; Bard, M. Cloning and sequencing of the Candida albicans C-4 sterol methyl oxidase gene (ERG25) and expression of an ERG25 conditional lethal mutation in Saccharomyces cerevisiae. Lipids 2000, 35, 257–262. [Google Scholar] [CrossRef]
- Hirano, T.; Sato, T.; Enei, H. Isolation of genes specifically expressed in the fruit body of the edible basidiomycete Lentinula edodes. Biosci. Biotechnol. Biochem. 2004, 68, 468–472. [Google Scholar] [CrossRef]
- Sunagawa, M.; Magae, Y. Isolation of genes differentially expressed during the fruit body development of Pleurotus ostreatus by differential display of RAPD. FEMS Microbiol. Lett. 2005, 246, 279–284. [Google Scholar] [CrossRef]
- De Groot, P.W.; Schaap, P.J.; van Griensven, L.J.; Visser, J. Isolation of developmentally regulated genes from the edible mushroom Agaricus bisporus. Microbiology 1997, 143, 1993–2001. [Google Scholar] [CrossRef]
- Iandolino, A.; da Silva, F.G.; Lim, H.; Choi, H.; Williams, L.; Cook, D. High-quality RNA, cDNA, and derived EST libraries from grapevine (Vitis vinifera L.). Plant Mol. Biol. Report. 2004, 22, 269–278. [Google Scholar] [CrossRef]
- Deokar, A.A.; Kondawar, V.; Jain, P.K.; Karuppayil, S.M.; Raju, N.; Vadez, V.; Varshney, R.K.; Srinivasan, R. Comparative analysis of expressed sequence tags (ESTs) between drought-tolerant and-susceptible genotypes of chickpea under terminal drought stress. BMC Plant Biol. 2011, 11. [Google Scholar] [CrossRef]
- Houde, M.; Belcaid, M.; Ouellet, F.; Danyluk, J.; Monroy, A.F.; Dryanova, A.; Gulick, P.; Bergeron, A.; Laroche, A.; Links, M.G. Wheat EST resources for functional genomics of abiotic stress. BMC Genomics 2006, 7. [Google Scholar] [CrossRef]
- ORF Finder. Available online: http://www.ncbi.nlm.nih.gov/gorf/gorf.html (accessed on 8 October 2013).
- BLASTX. Available online: http://www.ncbi.nlm.nih.gov/BLAST (accessed on 19 October 2013).
- Gene Ontology Consortium. Available online: http://www.geneontology.org (accessed on 31 October 2013).
- COGs—Clusters of Orthologous Groups. Available online: http://www.ncbi.nlm.nih.gov/COG/ (accessed on 10 November 2013).
- Pfaffl, M.W.; Tichopad, A.; Prgomet, C.; Neuvians, T.P. Determination of stable housekeeping genes, differentially regulated target genes and sample integrity: BestKeeper-Excel-based tool using pair-wise correlations. Biotechnol. Lett. 2004, 26, 509–515. [Google Scholar] [CrossRef]
- Pfaffl, M.W. A new mathematical model for relative quantification in real-time RT–PCR. Nucleic Acids Res. 2001, 29, e45–e45. [Google Scholar] [CrossRef]
© 2014 by the authors; licensee MDPI, Basel, Switzerland. This article is an open access article distributed under the terms and conditions of the Creative Commons Attribution license (http://creativecommons.org/licenses/by/3.0/).
Share and Cite
Song, C.; Liu, M.; Xing, Y.; Guo, S. ESTs Analysis of Putative Genes Engaged in Polyporus umbellatus Sclerotial Development. Int. J. Mol. Sci. 2014, 15, 15951-15962. https://doi.org/10.3390/ijms150915951
Song C, Liu M, Xing Y, Guo S. ESTs Analysis of Putative Genes Engaged in Polyporus umbellatus Sclerotial Development. International Journal of Molecular Sciences. 2014; 15(9):15951-15962. https://doi.org/10.3390/ijms150915951
Chicago/Turabian StyleSong, Chao, Mengmeng Liu, Yongmei Xing, and Shunxing Guo. 2014. "ESTs Analysis of Putative Genes Engaged in Polyporus umbellatus Sclerotial Development" International Journal of Molecular Sciences 15, no. 9: 15951-15962. https://doi.org/10.3390/ijms150915951
APA StyleSong, C., Liu, M., Xing, Y., & Guo, S. (2014). ESTs Analysis of Putative Genes Engaged in Polyporus umbellatus Sclerotial Development. International Journal of Molecular Sciences, 15(9), 15951-15962. https://doi.org/10.3390/ijms150915951
